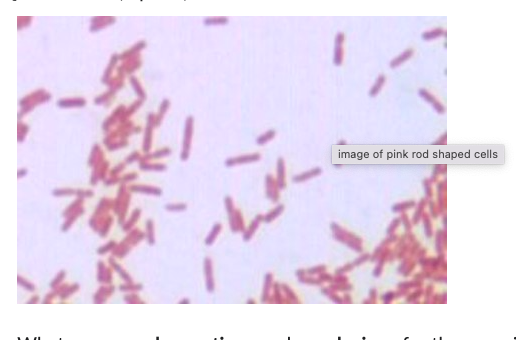
Solved What Is The Mechanism Of Endospore Stain And Or Cheggcom

In addition to the information above, here is a curated collection of images related to Solved What Is The Mechanism Of Endospore Stain And Or Cheggcom.
- Solved . Outline The Steps Involved In An Endospore Stain | Chegg.Com
- Solved 3. Consider The Endospore Stain. A. A Positive Result | Chegg.Com
- Solved What Additional Step Is Needed During The Endospore | Chegg.Com
- Solved Gram Stain Reaction Endospore Stain And Cell | Chegg.Com
- SOLVED: Endospore Stain Questions What Would Happen If You Did Not Heat ...
Find More About "Solved What Is The Mechanism Of Endospore Stain And Or Cheggcom"
Explore exclusive offers, detailed information, and related services about solved what is the mechanism of endospore stain and or cheggcom from our trusted partners.
View Special Offers